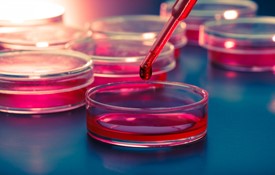
Cái nhìn về tế bào gốc trị liệu

Loãng xương: những đóng góp của Việt Nam cho thế giới
16/07/2018
Tóm tắt: Loãng xương là một bệnh lí phức tạp trong nhóm các bệnh không lây nhiễm, với đặc điểm chính là sức mạnh của xương bị suy giảm theo độ tuổi và dẫn đến tăng nguy cơ gãy xương. Gãy xương là một trong những gánh nặng lớn cho bệnh nhân, gia đình, và xã hội. Ở Việt Nam, có khoảng 1/4 phụ nữ và 1/10 nam giới cao tuổi bị loãng xương. Trong thời gian 10 năm qua, đã có nhiều tiến bộ về hiểu biết và điều trị bệnh loãng xương. Ngoài ra, nhiều nghiên cứu từ Việt Nam cũng đã có những đóng góp quan trọng cho chuyên ngành loãng xương trên thế giới. Bài viết này trình bày những điểm chính trong tiến bộ về loãng xương và những đóng góp của Việt Nam.

Chuyên ngành loãng xương có gì mới?
16/07/2018
Chuyên ngành loãng xương có gì mới? Câu trả lời là dĩ nhiên có rất nhiều cái mới. Một chuyên ngành có hàng chục tập san khoa học xuất bản hàng tháng thì lúc nào mà chẳng có cái mới. Vấn đề là cái mới đó nó có ảnh hưởng hay gây tác động đến việc quản lí, chẩn đoán và điều trị bệnh hay không. Cái mới liên quan đến những khía cạnh thực tế này thì quả thật là hơi hiếm. Nhân dịp sắp tới hội nghị loãng xương ở Đà Lạt (8/2018), tôi xin chia sẻ cùng các bạn vài tiến bộ mới mà tôi nghĩ là ngoạn mục và có ý nghĩa trong thực hành lâm sàng.

Phát triển tiêu chuẩn tỉ trọng mỡ cơ thể cho chẩn đoán béo phì ở người việt
05/07/2018
Mục tiêu của công trình nghiên cứu này là khảo sát mối tương quan giữa chỉ số khối cơ thể (BMI) và tỉ trọng mỡ cơ thể (percentage body fat, hay PBF), và qua đó tìm một chuẩn mới của PBF để chẩn đoán béo phì cho người Việt.

Chẩn đoán gãy xương đốt sống: Phần 2. Quy mô gãy xương đốt sống ở người Việt
05/07/2018
Mục tiêu. Gãy xương đốt sống là một biểu hiện cổ điển của loãng xương, vì không có triệu chứng. Mục tiêu của nghiên cứu này là để xác định tỉ lệ hiện hành gãy xương đốt sống ở nam và nữ tại Thành phố Hồ Chí Minh.

Chẩn đoán gãy xương đốt sống: Phần 1. Phát triển giá trị tham chiếu cho người Việt
05/07/2018
Mục tiêu nghiên cứu. Gãy xương đốt sống xảy ra một cách âm thầm vì không có triệu chứng đáng chú ý. Phương pháp chẩn đoán gãy xương đốt sống chính xác nhất là dựa vào định lượng chiều cao của mỗi đốt sống. Nghiên cứu này có mục tiêu phát triển giá trị tham chiếu để phục vụ cho việc chẩn đoán gãy xương đốt sống ở người Việt.

Loãng xương ở nam giới
25/06/2018
Tóm lược Loãng xương thường được xem là một bệnh của nữ giới. Tuy nhiên, nhiều nghiên cứu trong mấy năm gần đây cho thấy đó là một sự ngộ nhận tai hại. Trong thực tế, loãng xương ở nam giới cũng là một vấn đề y tế quan trọng. Nghiên cứu của chúng tôi cho thấy một đàn ông trung bình ở độ tuổi 50, nguy cơ bị gãy xương trong quãng đời còn lại là khoảng 25%. Khoảng 1/3 các ca gãy xương hông (hip fractures) xảy ra ở nam giới. Bởi vì đàn ông có mật độ xương (MĐX) cao hơn nữ, và họ cũng có tỉ lệ mất xương thấp hơn nữ, cho nên gãy xương ở đàn ông thường hay thấy trong các độ tuổi khá cao (trên 70). Hệ quả gãy xương ở nam giới thường nghiêm trọng hơn ở nữ giới. Khoảng 30% đàn ông chết sau 12 tháng bị gãy xương hông, trong khi đó tỉ lệ này ở nữ là 12%.

Thay đổi mật độ xương ở phụ nữ sau mãn kinh: Yếu tố nguy cơ
25/06/2018
Mục tiêu. Phụ nữ trong độ tuổi mãn kinh thường mất mật độ xương và tăng nguy cơ gãy xương. Mật độ xương ở người ăn chay thấp hơn so với người ăn mặn. Vì chưa có nghiên cứu nào về tỷ lệ mất xương ở người Việt, chúng tôi thực hiện công trình nghiên cứu này với hai mục đích: (i) ước lượng tỷ lệ mất xương trong nhóm ăn chay và ăn mặn; và (ii) tìm hiểu yếu tố tiên lượng mất xương ở những phụ nữ này.

Gãy xương cột sống do loãng xương
21/04/2019
Loãng xương là một bệnh làm xương yếu và dễ gãy – kết quả là gãy xương (được biết tới là gãy xương do loãng xương). Gãy xương cột sống do loãng xương là một trong những nguyên nhân chính gây đau, tàn tật và đó cũng là một yếu tố dự báo mạnh mẽ cho khả năng gãy xương trong tương lai. Thế nhưng, gãy xương cột sống lại thường không được chẩn đoán, cũng như xác định nguyên nhân để điều trị tận gốc. Điều này đặt bệnh nhân vào nguy hiểm vì có thể phải chịu đựng thêm hàng loạt gãy xương nữa.
Cái nhìn về tế bào gốc trị liệu
08/04/2019
Tế bào gốc có lẽ là chuyện thời sự khoa học không chỉ ở các nước phương Tây, mà còn rất được quan tâm ở trong nước. Hôm thứ Hai, tôi có dịp đi nghe một bài nói chuyện thú vị về triển vọng của tế bào gốc, và hôm nay mới có thì giờ thuật lại câu chuyện. Diễn giả là John Rasko, giáo sư y khoa thuộc Đại học Sydney và ngôi sao trong 'làng' tế bào gốc (1). Ông đưa ra nhiều cảnh cáo về những người mà ông gọi là "shonky operator", ý nói những người làm bậy bạ và gây tác hại đến bệnh nhân.


